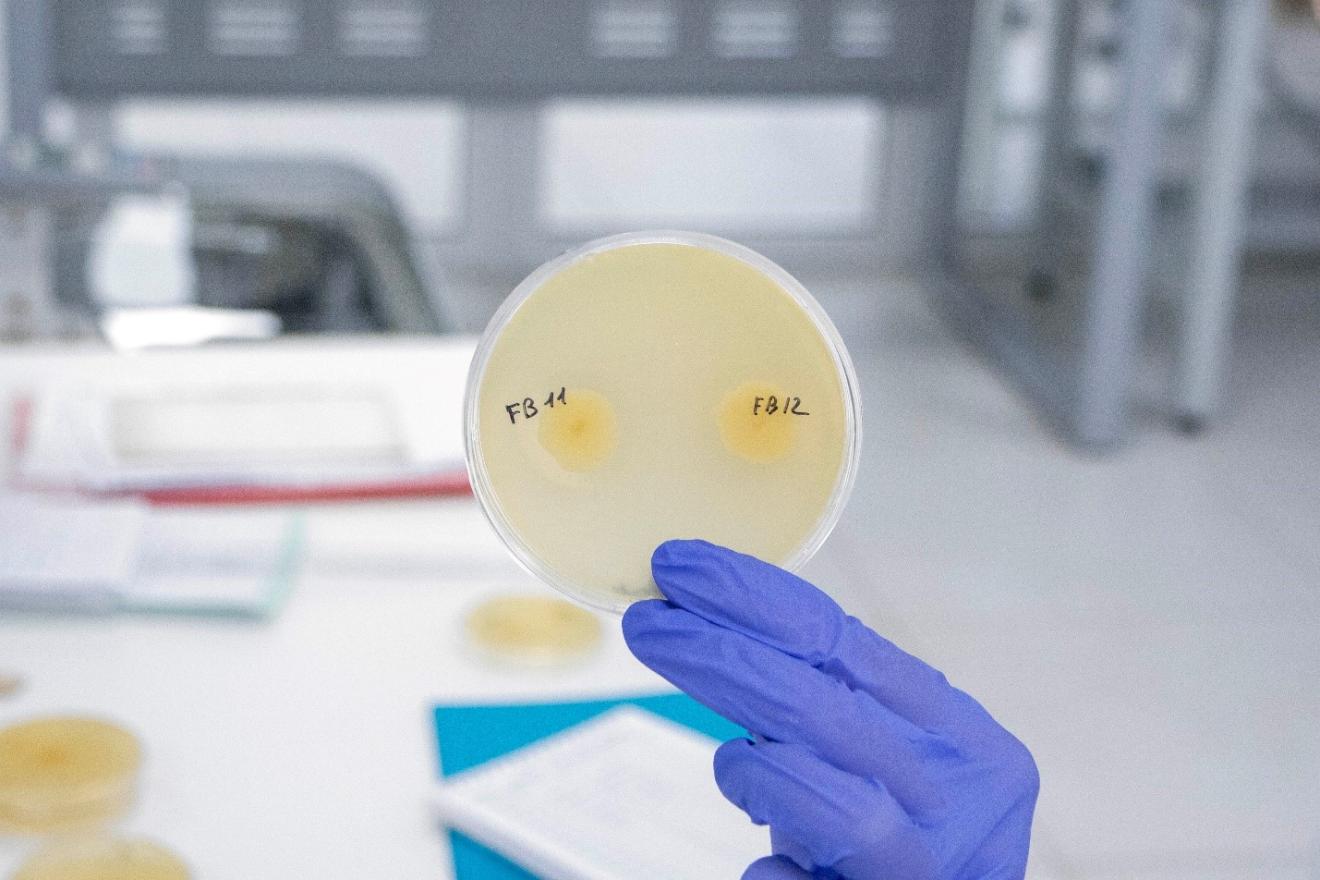
Ученые ДГТУ создают уникальные корма с пробиотиками для выращивания раков и креветок

Обеспечение страны продуктами питания – задача, в которой аквакультура играет все более заметную роль. Рыба, креветки, раки – спрос на них растет, а значит, нужны современные технологии для выращивания гидробионтов. Один из эффективных способов повысить продуктивность – использовать специальные кормовые добавки, в том числе пробиотики, которые благотворно влияют на здоровье организмов.
В России в последние годы активно развивается направление по выращиванию ракообразных. Особый интерес у фермеров вызывают австралийский красноклешневый рак (Cherax quadricarinatus) и гигантская пресноводная креветка (Macrobrachium rosenbergii). Однако масштабировать такое производство мешают сразу две проблемы: нет научно обоснованных рецептов комбикормов, адаптированных именно под этих животных, и практически отсутствуют специализированные пробиотические добавки, которые помогли бы ракам и креветкам лучше усваивать питательные вещества и реже болеть.
Именно эти задачи в 2025 году взял на себя научный коллектив Донского государственного технического университета под руководством кандидата технических наук Татьяны Мальцевой. Исследование поддержано грантом Российского научного фонда (соглашение № 25-76-10094 от 10.09.2025). Ученые работают над созданием комбикормов с выраженной пробиотической активностью для перспективных объектов аквакультуры.

На сегодняшний день мы уже разработали несколько рецептур, которые проходят лабораторные испытания. Часть из них показывает высокую эффективность, и мы рассматриваем их как перспективных кандидатов для внедрения в производство.
Особая гордость команды – собственные бактериальные штаммы, выделенные из кишечной микробиоты самих ракообразных.
Нами выделены бактерии с ярко выраженными пробиотическими свойствами. Эти изоляты эффективно расщепляют белок и клетчатку благодаря выработке особых ферментов. Это позволяет создать продукцию нового поколения, которая поможет повысить выживаемость и продуктивность раков и креветок в условиях акваферм.
Работа донских ученых – это не просто создание кормов. Речь идет о переходе от эмпирического подхода к наукоемким биотехнологическим решениям. Разработка специализированных комбикормов и пробиотиков снижает зависимость от импорта и закладывает основу для стабильного и рентабельного производства таких ценных объектов, как австралийский красноклешневый рак и гигантская пресноводная креветка.